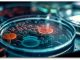

Според астролозите, жените родени во овие хороскопски знаци се украсени со интелигенција, способност да се справат во секоја ситуација и високо ниво на организација.
Нема нешто што не можат да постигнат. Овие жени се навистина посебни:
Овен
Жените овни се многу одговорни и веруваат дека го држат животот во свои раце. Оние трпеливо и високо подигнати глави ги добиваат сите тешкотии што им ги наметнува судбината. Жените родени во овој знак се среќни да им помагаат и да се грижат за другите. Тие сакаат да го запознаваат светот, да читаат и да имаат многу хобија, и сите овие се добри извори од кои може да се извлече животна мудрост.
Бик
Ако навистина ви треба мудар совет за врските, контактирајте жена бик. Таа со задоволство ќе го сподели своето искуство и знаење со другите. Биковите поседуваат внатрешен мир и добрина и великодушно ја даваат својата топлина на својата околина. Жената бик може да биде муза на својот маж затоа што секогаш ќе ги поддржува неговите амбиции и ќе биде сигурна поддршка во семејниот живот.
Девица
Жените родени во овој знак на земјата рационално го прифаќаат животот и такви се и нивните одлуки. Тие се многу разумни и трпеливи луѓе. На некои животни ситуации честопати пристапуваат како набљудувач. Благодарение на тоа, тие многу гледаат и разбираат. Мудрата жена девица е мирна и знае како да ги контролира своите емоции. Иако е многу силна, таа знае како да се однесува нежно и женствено.